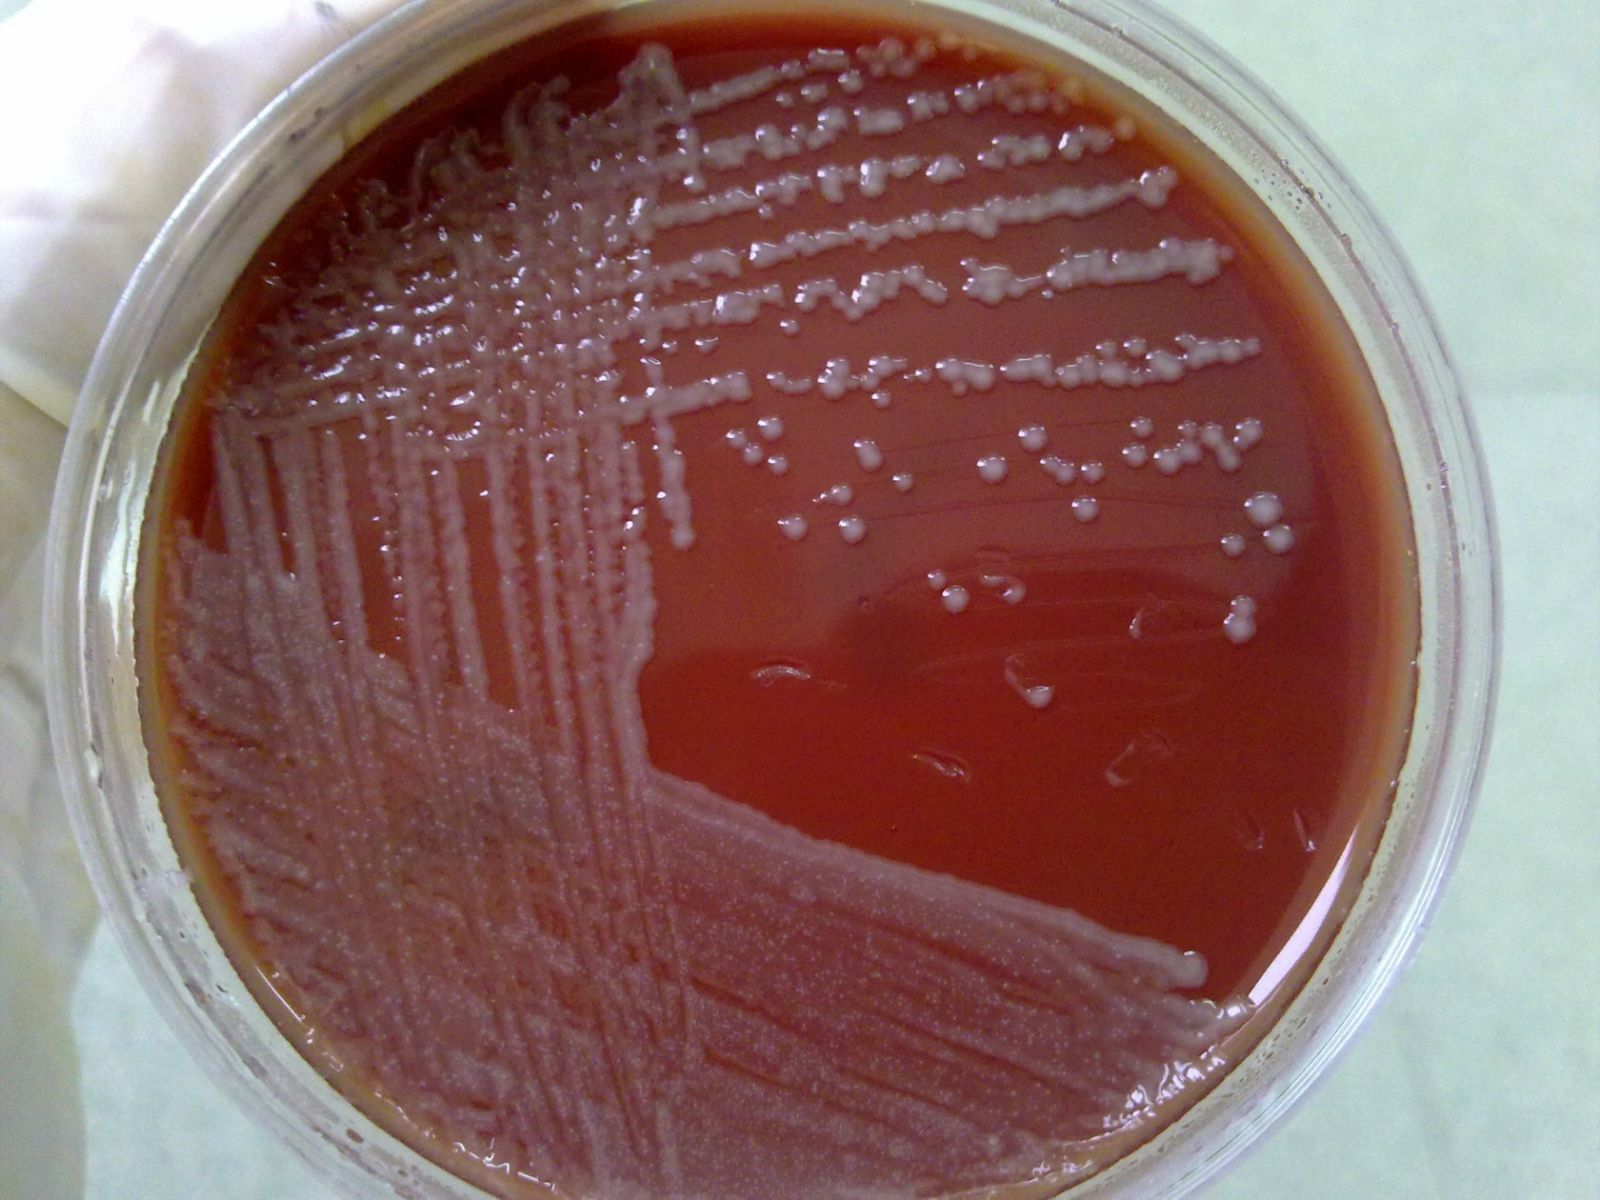

(一)发病原因
巴斯德菌属包括出血败血性巴斯德菌,又称多杀巴斯德菌,它是鸡霍乱、哺乳动物出血败血症和人类许多传染病的病原菌;其他种有侵肺巴斯德菌、溶血巴斯德菌(P.hemolytica)和脲巴斯德菌(P.ureue)。出血败血性巴斯德菌是一小的双极着色的革兰阴性球杆菌,在含血清琼脂中生长良好,但在Mac Conkey培养基中生长受抑。此菌可产生荚膜,干扰白细胞的吞噬作用。在土壤和水中可存活3周,动物尸体内可存活2月之久。
(二)发病机制
出血败血性巴斯德菌含有多糖荚膜,干扰白细胞的吞噬作用,此外,此菌能产生内毒素。出血败血性巴斯德菌肺炎大多发生于慢性肺部疾病患者,细菌经口鼻、咽部吸入后,可在肺部繁殖,破坏肺组织,进一步可引起肺组织坏死、肺脓肿形成、肺气肿及败血症,20%的病例可累及胸膜,但因胸膜下的病灶易形成局限性坏死性肺炎,故脓胸较少发生,但可直接经支气管播散影响其他肺段。